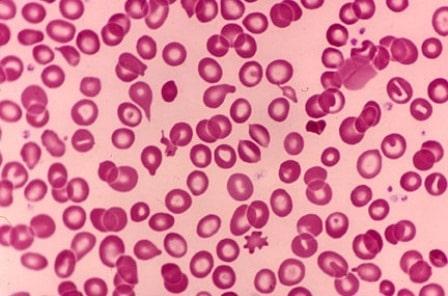
%e1%80%9e%e1%80%9a%e1%80%b9%e1%80%9c%e1%80%b9%e1%80%86%e1%80%ae%e1%80%b8%e1%80%99%e1%80%ae%e1%80%b8%e1%80%9a%e1%80%ac%e1%80%b8-thalassemia-%e1%80%b1%e1%80%9b%e1%80%ac%e1%80%82%e1%80%ab-%e1%80%a1

ဘာလို့ တစ်ချိန်လုံး ချမ်းနေရတာလဲ
ဆောင်းရာသီ လူတိုင်း ချမ်းတဲ့အချိန်မှာ ချမ်းတာ ပုံမှန်ပဲလို့ ဆိုနိုင်ပေမယ့် နွေခေါင်ခေါင် လူတိုင်း ပူနေချိန်မှာ ချမ်းတယ်လို့ ခံစားနေရမယ်။ အချိန်တိုင်းလိုလို ချမ်းနေမယ်ဆိုရင်တော့ ကျန်းမာရေး ပြဿနာ ရှိနေတာ ဖြစ်နိုင်ပါတယ်။ ဘာလို့ တစ်ချိန်လုံး ချမ်းနေရတာလဲ ဆိုတာကို မသိချင်ဘူးလား ...... ဘာလို့ တစ်ချိန်လုံး ချမ်းနေရတာလဲ ဆိုတဲ့ အဖြေကို သိနိုင်ဖို့ ဆောင်းပါးလေး ဖတ်ကြည့်စေချင်ပါတယ်။ ဆောင်းပါးလေး ဖတ်ရင်း အတူတူ အဖြေရှာ ကြည့်လိုက်ရအောင်လား။ ဘာလို့ တစ်ချိန်လုံး ချမ်းနေရတာလဲ တစ်ချိန်လုံး ချမ်းတယ်လို့ ခံစားနေရတာ ဒီအချက်တွေကြောင့်ပါ။ သွေးအားနည်း ရောဂါ ရှိတာ ကိုယ်ထဲမှာ သွေးနီဥဆဲလ်တွေ လုံလုံလောက် မရှိတဲ့ အခါ အဆုတ်နဲ့ အခြား ခန္ဓာကိုယ် အစိတ်အပိုင်းတွေဆီကို အောက်ဆီဂျင် လုံလောက်စွာ ရရှိဖို့ ခက်ခဲသွားပါတယ်။ ဒီအခြေအနေကို […]